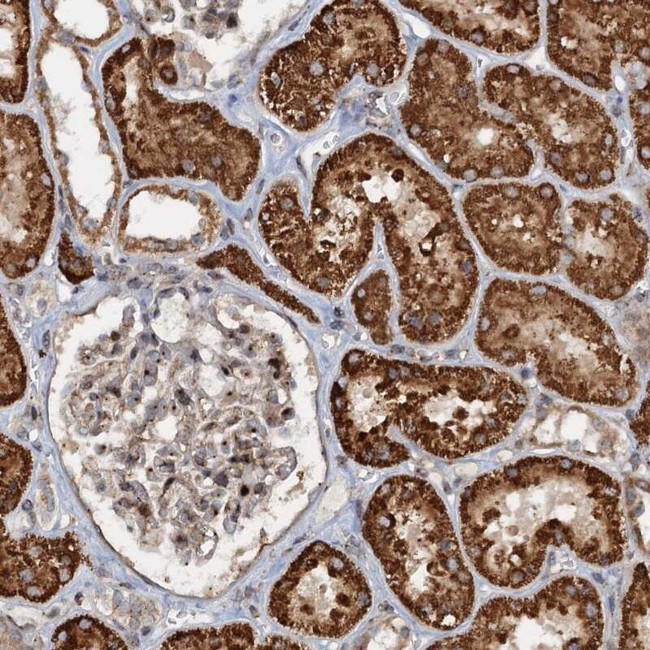
CEP68 Antibody in Immunohistochemistry (IHC)
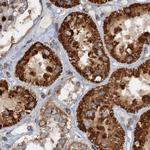
CEP68 Antibody in Immunohistochemistry (IHC)
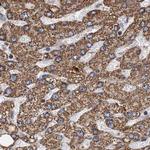
CEP68 Antibody in Immunohistochemistry (IHC)

Search
Invitrogen
CEP68 Polyclonal Antibody
{{$productOrderCtrl.translations['antibody.pdp.commerceCard.promotion.promotions']}}
{{$productOrderCtrl.translations['antibody.pdp.commerceCard.promotion.viewpromo']}}
{{$productOrderCtrl.translations['antibody.pdp.commerceCard.promotion.promocode']}}: {{promo.promoCode}} {{promo.promoTitle}} {{promo.promoDescription}}. {{$productOrderCtrl.translations['antibody.pdp.commerceCard.promotion.learnmore']}}
产品信息
PA5-59227
种属反应
宿主/亚型
分类
类型
抗原
偶联物
形式
浓度
规格
纯化类型
保存液
内含物
保存条件
运输条件
RRID
产品详细信息
Immunogen sequence: GSPQLRTRDR GWPSPRPERE KRTSQSARRP TCTESRWKSE EEVESDDEYL ALPARLTQVS SLVSYLGSIS TLVTLPT
Highest antigen sequence identity to the following orthologs: Mouse - 56%, Rat - 62%.
靶标信息
Centrosomal protein of 68 kDa is a protein that in humans is encoded by the CEP68 gene. It is mapped to chromosome 2. CEP68 is required for centrosome cohesion. It decorates fibres emanating from the proximal ends of centrioles. CEP68 and rootletin depend both on each other for centriole association, and both also require CEP250 for their function.
仅用于科研。不用于诊断过程。未经明确授权不得转售。
篇参考文献 (0)
生物信息学
蛋白别名: centrosomal protein 68kDa; Centrosomal protein of 68 kDa; Cep68; unnamed protein product
基因别名: CEP68; KIAA0582
UniProt ID: (Human) Q76N32
Entrez Gene ID: (Human) 23177